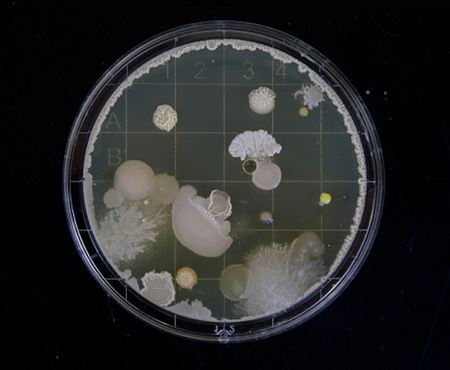

Candida auris devient de plus en plus fréquente.

Le Candida auris est une levure pathogène qui provoque des infections fongiques. Vous en avez probablement entendu parler dans les actualités ces dernières semaines : le Candida auris. Le nom peut sembler poétique, mais il ne l'est absolument pas. What's in a name? Celui-ci s'est manifesté pour la première fois de manière visible en 2009 dans le conduit auditif externe d'une femme japonaise (auris signifie oreille en latin, d'où le nom).
Qu'est-ce que le Candida auris ?
Le Candida auris est une levure pathogène qui provoque des infections fongiques. L'infection est problématique en raison de certaines caractéristiques extrêmement désagréables. Tout d'abord, elle est particulièrement difficile à combattre car elle peut survivre à la fois à l'intérieur et à l'extérieur du corps. Cela lui permet de se propager extrêmement rapidement. Ainsi, elle peut se propager dans les établissements de soins via les dispositifs médicaux et les surfaces. Les personnes ayant une bonne immunité ne sont généralement pas affectées par le Candida auris. En revanche, les personnes avec un système immunitaire affaibli ne peuvent pas éliminer le champignon elles-mêmes et peuvent en souffrir sérieusement. Dans certains cas, cela peut même être fatal. Les champignons sont une cause de mortalité plus importante dans le monde que le paludisme. Il y a aussi peu de moyens pour lutter contre une fois que le champignon est dans la circulation sanguine, car de nombreux champignons, y compris ce Candida auris, ont une grande résistance aux médicaments.
Comment contracte-t-on le Candida auris ?
Étant donné que le champignon peut survivre sur les poignées de porte, la literie et d'autres surfaces, une mauvaise hygiène est une cause majeure d'infections. De plus, les personnes (même en bonne santé) qui sont porteuses du champignon peuvent le transmettre. Une fois infecté, il est difficile de combattre le champignon. C'est pourquoi la prévention et la désinfection sont extrêmement importantes pour éviter une infection par le champignon.
Comment prévenir le Candida auris ?
La désinfection et de bonnes normes d'hygiène sont les meilleurs moyens de prévenir le Candida auris. Le champignon peut survivre jusqu'à 2 semaines sur des surfaces avec un bon milieu nutritif. Il est donc essentiel de bien désinfecter dans les environnements où se trouvent de nombreuses personnes avec une santé fragile. Cela signifie non seulement utiliser les bons agents à large spectre avec une action active contre les levures, mais aussi respecter correctement le dosage et le temps de contact. En utilisant un bon désinfectant et un plan de désinfection approprié, vous pouvez limiter la contamination via les surfaces et les dispositifs médicaux.
Le choix du désinfectant approprié dépend de plusieurs facteurs. Surface, matériau, rinçage,...
Prenez contact avec nous et nous trouverons ensemble la meilleure solution pour vous !